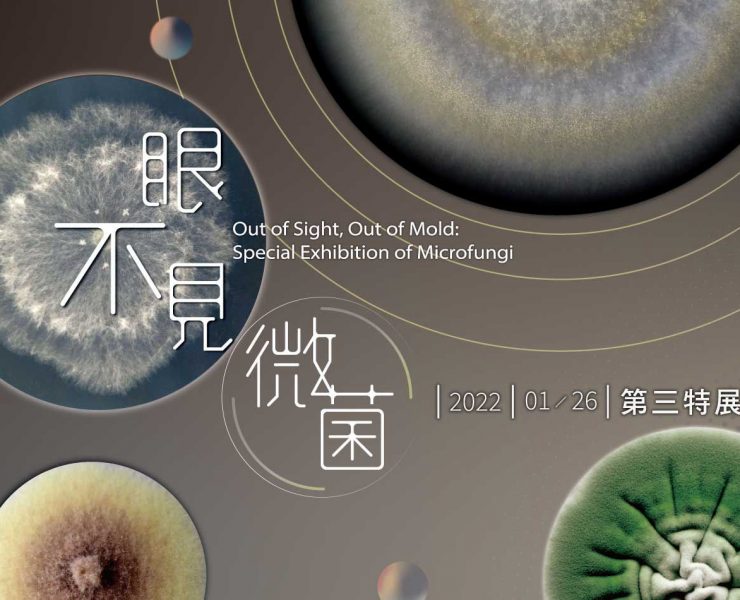

小典藏ArtcoKids|小編報報
喜歡藝術,熱愛繪本,最愛閱讀,還有開懷大笑的小孩笑容! 每天都愛四處看東看西趴趴走,要把最新鮮有趣好看好玩的內容分享給大家!
★按讚FB→https://www.facebook.com/artcokids/
▲來追IG→ https://www.instagram.com/artcokids/
■聽PODCAST→ https://open.firstory.me/user/artcokids
◎加LINE@→https://line.me/R/ti/p/@hmo6185j
◣一起玩→ 合作洽談 artcokids@gmail.com